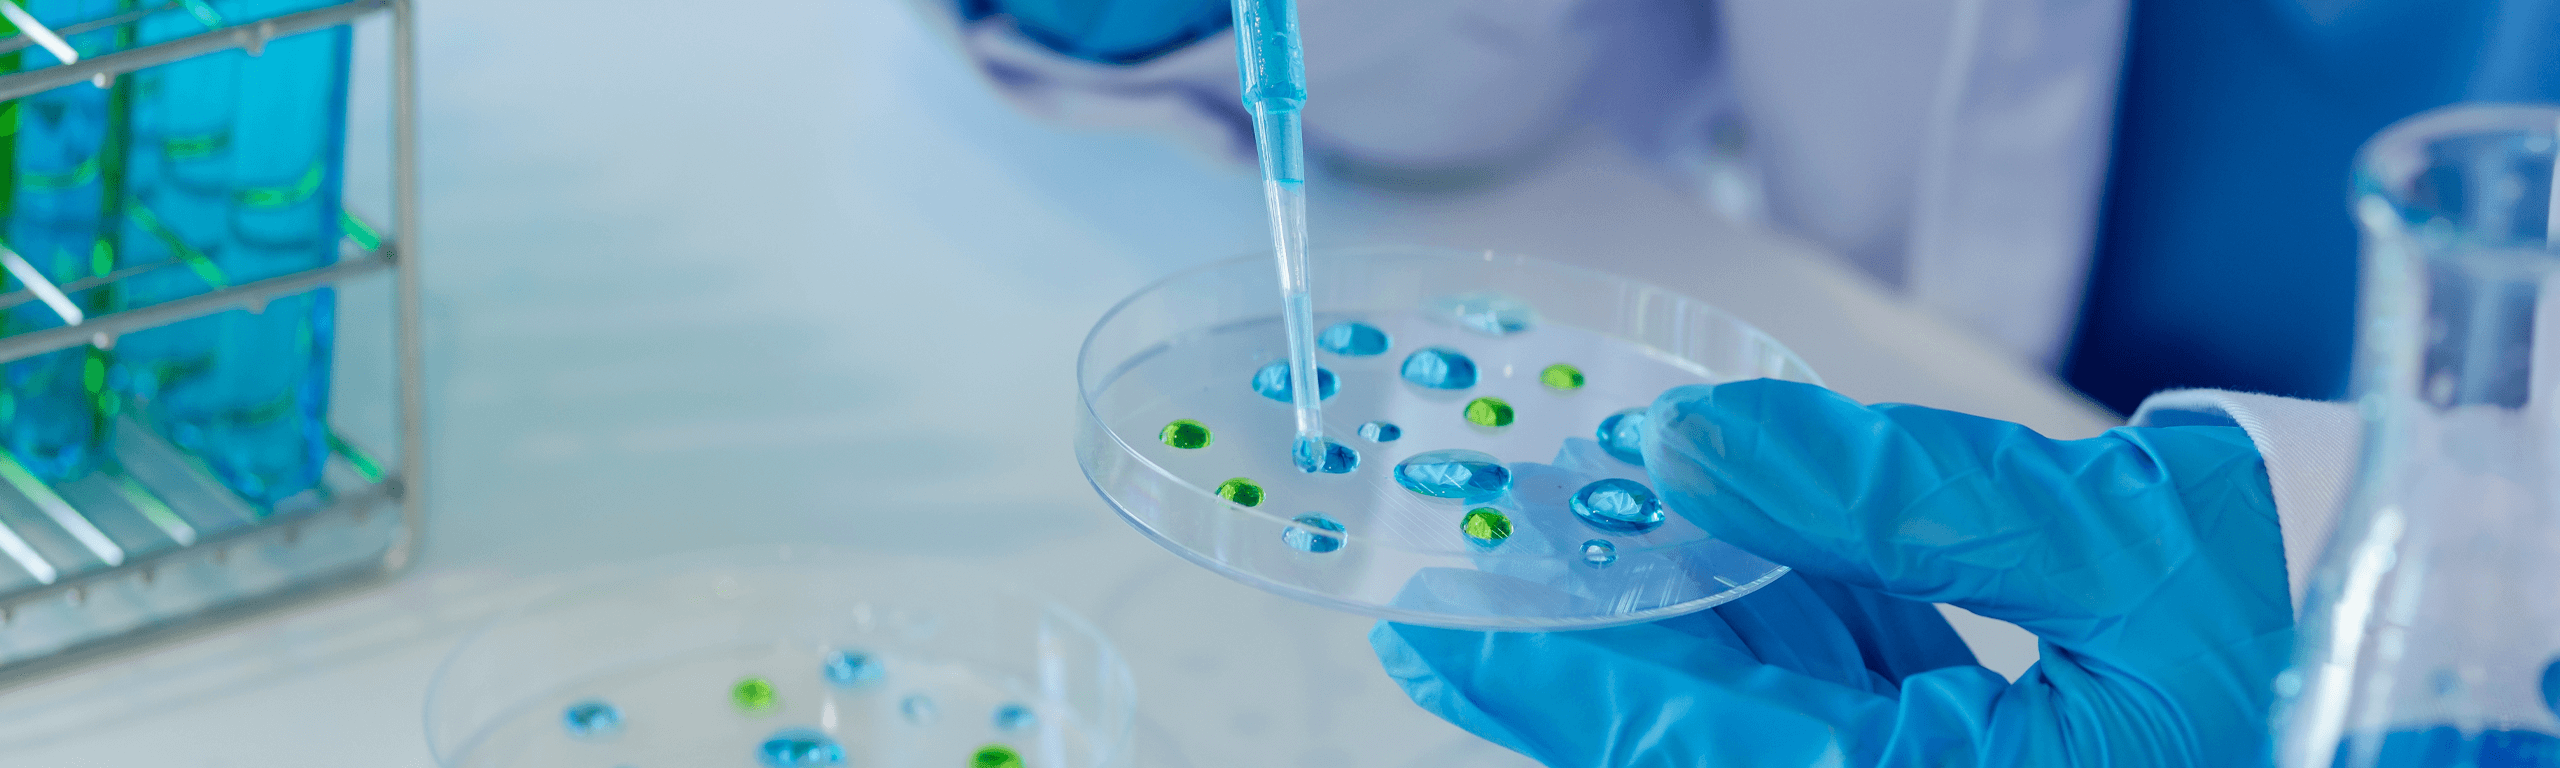
Ιατρική Φυσική

Σκοπός του Τμήματος Ιατρικής Φυσικής είναι να διασφαλίζει την ποιοτική απόδοση, την ακριβή δοσιμετρία ακτινοβολιών και την ακτινοπροστασία των μηχανημάτων και συσκευών παραγωγής και μέτρησης ιοντιζουσών ακτινοβολιών, που χρησιμοποιούνται στα τμήματα του Metropolitan Hospital για διαγνωστικούς και θεραπευτικούς σκοπούς. Είναι επίσης υπεύθυνο για την δοσιμετρία του προσωπικού και των ασθενών.
Στον τομέα των θεραπευτικών εφαρμογών (Εξωτερική Ακτινοθεραπεία και Βραχυθεραπεία) κύριος στόχος είναι η σχεδίαση της βέλτιστης τεχνικής ακτινοβόλησης, ο ακριβής δοσιμετρικός υπολογισμός του πλάνου θεραπείας, η εφαρμογή, η επιβεβαίωση και η εκτέλεση της θεραπείας με πιστότητα και ασφάλεια.
Το Τμήμα Ιατρικής Φυσικής εφαρμόζει τις πιο σύγχρονες τεχνικές ακτινοθεραπείας σε συνεργασία με το Κέντρο Ακτινοθεραπευτικής Ογκολογίας (ΚΑΟ) του Metropolitan Hospital. Η Σύμμορφη Τρισδιάστατη Ακτινοθεραπεία (3DCRT), η Ακτινοθεραπεία Διαμορφωμένης Έντασης (IMRT) με τη βοήθεια απεικονιστικής και αναπνευστικής καθοδήγησης (IGRT-RPM), η ενδοκρανιακή και εξωκρανιακή Στερεοτακτική Ακτινοθεραπεία (SRT) καθώς και η Στερεοτακτική Ακτινοχειρουργική (SRS) σε συνεργασία με την Νευροχειρουργική Κλινική, η βραχυθεραπεία μεταφόρτισης υψηλού ρυθμού δόσης καθοδηγούμενη από εικόνες αξονικού και μαγνητικού τομογράφου (CT-MRI based brachytherapy), η δυναμική και πραγματικού χρόνου βραχυθεραπεία προστάτη με μόνιμα ραδιενεργά εμφυτεύματα σε συνεργασία με την Ουρολογική Κλινική και in vivo δοσιμετρία της ουρήθρας είναι τεχνικές που πραγματοποιούνται στο Metropolitan Hospital, καθιστώντας το έτσι ένα από τα πιο σύγχρονα τμήματα Ιατρικής Φυσικής στην Ευρώπη.
Στον τομέα των διαγνωστικών εφαρμογών, (ακτινολογικές εξετάσεις, μαστογραφία, αξονική τομογραφία, μέτρηση οστικής πυκνότητας, ραδιοϊσοτοπικές εξετάσεις) όπου η ανάγκη για την λήψη διαγνωστικών πληροφοριών και εικόνων υψηλής ποιότητος είναι μεγίστης σημασίας, το Τμήμα Ιατρικής Φυσικής διασφαλίζει ότι οι διαγνωστικές εξετάσεις επιβαρύνουν με την ελάχιστη αποδεκτή δόση ακτινοβολίας τους εξεταζόμενους και το προσωπικό.
Το Τμήμα είναι στελεχωμένο με έμπειρους ακτινοφυσικούς ειδικά εκπαιδευμένους στον τομέα εφαρμογών των ιοντιζουσών ακτινοβολιών στην Ιατρική, με άδεια ασκήσεως επαγγέλματος ακτινοφυσικού και μεταπτυχιακούς τίτλους σπουδών από την Ελλάδα και το εξωτερικό.